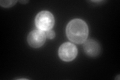

View description
Proteolipid associated with plasma membrane H(+)-ATPase (Pma1p); regulates plasma membrane H(+)-ATPase activity; nearly identical to PMP1
Localization:
Intensity:
Fold change:
Significance:
-
C’ GFP library in SD

vacuole, cell periphery460.51 -
N' NOP1pr-GFP in SD

punctate,vacuole membrane294.585 -
N' TEF2pr-mCherry in SD

ER,vacuole472.974 -
N' NATIVEpr-GFP in SD

punctate,vacuole membrane437.603 -
N' TEF2pr-VC and Cyto-VN in SD

#N/A0 -
C’ GFP library in SD+DTT

vacuole, cell periphery488.231.06No -
C’ GFP library in SD+H2O2
vacuole, cell periphery529.41.14No -
C’ GFP library in Starvation Media

vacuole, cell periphery619.951.34No -
C’ GFP library on the background of Pup2-DaMP

vacuole -
C’ GFP library on the background of CCT mutant

vacuole, cell periphery674.1011.46377Yes
